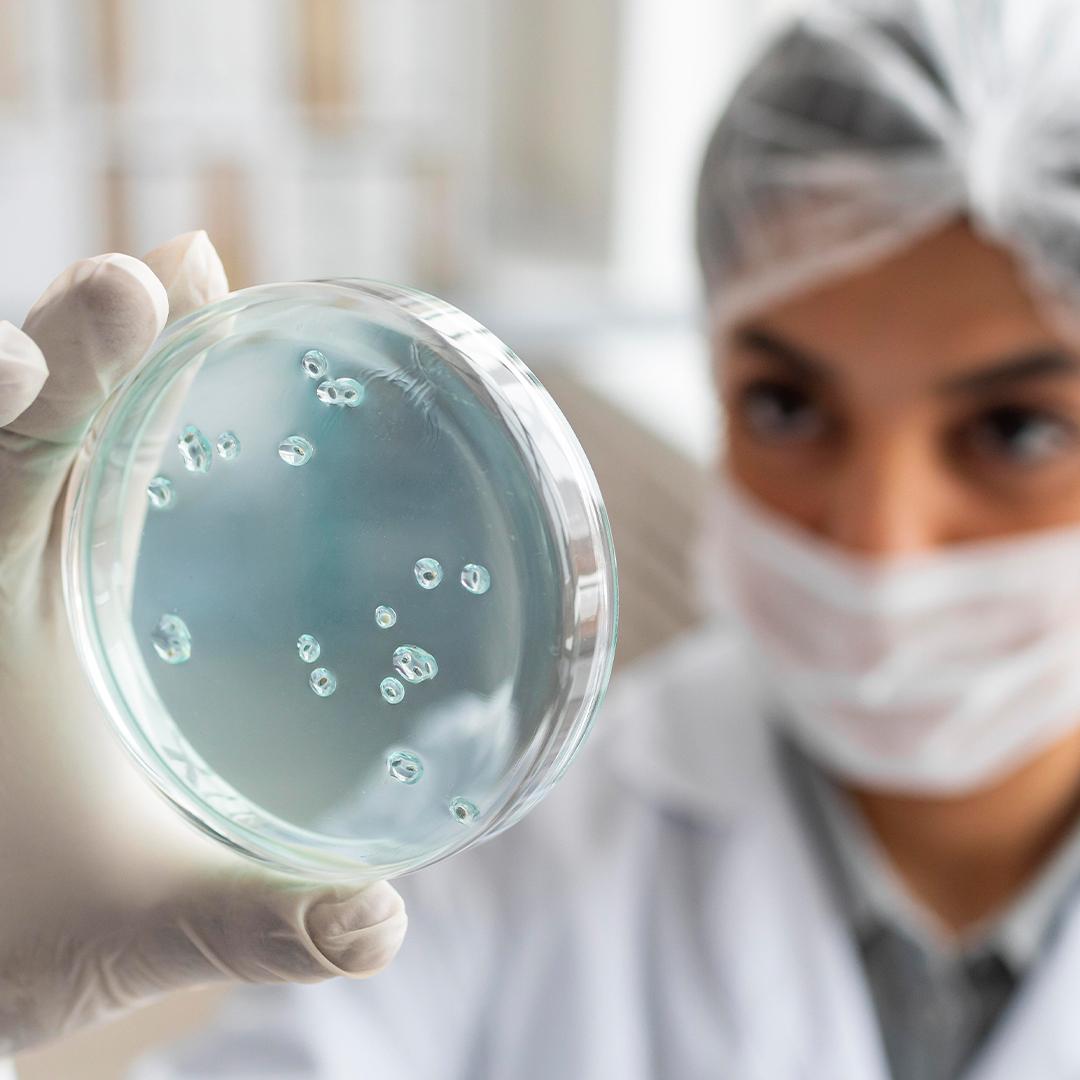
maya göz

Göz Hastalıklarında Eksozom Tedavisi: Bilimsel Bir Gerçek mi yoksa Ticari Bir Yaklaşım mı?
“Görmeye Umut, Hücreye Hayat!”
Kök hücre ve eksozom tedavileriyle göz hastalıklarında hücresel onarım mümkün! RP, YBMD, kuru göz, glokom ve daha fazlası için umut veren çözümler Mayagöz’de.
Göz hastalıklarında klasik tedavilere ek olarak geliştirilen kök hücre ve eksozom tedavileri, hasarlı dokuları onarma ve hücresel dengenin yeniden sağlanmasına yardımcı olan ve modern tıbbın en dikkat çekici gelişmeleri arasında yer alan tedavi yöntemleridir. Bilimsel çalışmalar, özellikle ilerleyici ya da klasik yöntemlerle yeterli sonuç alınamayan vakalarda bu tedavilerin önemli faydalar sağlayabileceğini ortaya koymaktadır.

Akıllı Lens Nedir?
Günümüzde görme problemlerinden kurtulmak ve yaşam kalitesini artırmak için en çok tercih edilen yöntemlerin başında akıllı lens (akıllı mercek) cerrahisi gelmektedir. Tıp dilinde trifokal (üç odaklı) lens olarak adlandırılan bu teknoloji, uzak, orta ve yakın mesafede gözlüksüz kesintisiz bir görüş sunmayı hedefler.
Akıllı lensler sadece katarakt hastaları için değil, gözlük bağımlılığından kurtulmak isteyen 45 yaş üstü bireyler için de ideal bir çözümdür.

Halk arasında göz çizdirme olarak da bilinen excimer lazer cerrahisi; kırma kusurları olan miyopi hipermetropi ve astigmatizmanın düzeltilmesi için gözün kornea (saydam) tabakası üzerine uygulanır. Korneanın yeniden şekillenmesi ve kırıcılık gücünde değişiklik yapılması göze zarar vermeden sağlanır.
Miyopi, hipermetropi ve astigmatizmada, gözlük ya da kontakt lens kullanmak istemeyen kişilerde, gözdeki kırma kusurları, Mayagöz kliniğimizde kişiye özel excimer lazer yöntemleri ile düzeltilir.
Excimer lazer, göz lazer cerrahilerinin temel cihazıdır. Farklı lazer cerrahilerinde farklı aşamalarda görev alır. PRK/LASEK/NoTouch/Streamlight gibi yüzey ablasyon tekniklerinde tek başına kullanılır iken FEMTOLASİK/İLASİK tekniklerinde önce femto lazer ile korneadan flap denilen üst tabaka ayrıştırılıp onun altında kalan tabakaya excimer lazer ile yine düzeltme işlemi gerçekleştirilir.

Katarakt, gözümüzün içinde doğuştan var olan merceğin şeffaflığını yitirmesi ve bunun sonucunda görme seviyesinde azalma, çift görme, ışık saçılması ve gözlük numarasının değişkenlik göstermesi ile karakterize bir durumdur. Katarakt her yaşta görülebilir, ancak ilerleyen yaş ana sebeptir.
Katarakt Belirtileri
Kataraktın belirtileri ve bulguları şöyledir;

Şaşılık, her iki gözün parelelliğini herhangi bir bakış pozisyonunda bozulması olarak adlandırılır. Şaşılıkta bir göz düz bakarken diğer göz içe, dışa, yukarı ve aşağı doğru kayabilir. Şaşılık daha çok çocuk yaş grubunu etkiler ancak yetişkinlerde de görülebilir.
Bebeklerde Şaşılık
Şaşılık bebek ve çocuklarda daimi olabileceği gibi, bazen yorgun ve uykulu durumlarda da görülebilir. Bu tür kaymalar kırma kusurlarının habercisi olabilir. Bu durumların tespit edilmesi açısından yaşamın ilk yılında ve daha sonraki yıllarda periyodik göz muayenesi yapılması önemlidir. Şaşılığın sadece estetik bir kusur olarak görülmesi bebek ve çocuklarda kendiliğinden düzelmesinin beklenilmesi doğru değildir. Amaç estetik kusurun düzelmesinden çok, her iki gözde fonksiyonel görmenin sağlanması, göz tembelliğinin önlenmesidir.

Çocuk Göz Sağlığı ve Erken Tanının Önemi
Çocuk göz sağlığı, erken dönemde yapılan kontrollerle ömür boyu sağlıklı bir görme gelişimini destekleyen en önemli faktörlerden biridir.
Çocuk göz muayenesi, yetişkin muayenesinden farklılık gösterir. Özellikle okul öncesi dönemde çocukların kendini ifade edememesi, muayenede korku veya uyumsuzluk yaşaması süreci zorlaştırabilir. Bu nedenle çocuk göz muayenesi, özel cihazlar ve deneyimli çocuk göz hastalıkları uzmanları tarafından yapılmalıdır.
Çocuk ve Bebeklerde Göz Muayenesinin Amacı
Bebek ve çocuklarda yapılan göz muayenelerinin temel amacı; mevcut göz ve görme problemlerini erken dönemde tespit ederek tedavi etmek ve göz tembelliği (ambliyopi) gibi kalıcı görme kayıplarının önüne geçmektir.

Oküloplasti, göz kapakları, gözyaşı sistemi ve göz çukuru (orbita) hastalıkları ve sorunlarıyla ilgilenen göz hastalıkları dalıdır. Bu kapsamda, göz kapaklarında yaşa bağlı olarak gelişebilecek değişiklikler, doğumsal ya da sonradan oluşan kapak düşüklükleri, göz kapağı çevresindeki ben (nevüs) ve kitleler, gözyaşı kanal tıkanıklıkları, tiroit hastalıklarında oluşabilecek orbita hastalıkları, orbita kitleleri cerrahi tedavi edilmektedir. Ayrıca protez göz uygulamaları da oküloplastinin konusudur. Oküloplastik cerrahi seçenekleri, estetik açıdan daha iyi bir görünüm sağladığı gibi daha konforlu bir görme alanı ve görme seviyesi sunmaktadır.

Nöro-Oftalmoloji: Göz ve Beyin Arasındaki Köprü
Nöro-oftalmoloji, görme sistemini sadece göz küresiyle sınırlı kalmayıp, gözden başlayıp beynin görme merkezine (oksipital korteks) kadar uzanan tüm sinir yollarını inceleyen uzmanlık dalıdır. Görme süreci; her iki gözün retinasından çıkan sinir liflerinin beyinle olan karmaşık iletişimi sayesinde gerçekleşir. Bu yollar üzerindeki herhangi bir aksama, ciddi görme kayıplarına neden olabilir.

Retina, gözün ışığı algılayan ağ tabakasıdır. Gözün tüm iç duvarını kaplar. Beyinden gelen damar ve sinirlerden oluşur. Retina muayenesi için görme derecesi ölçülüp biyomikroskopik muayeneden geçtikten sonra göz bebeğinin genişlemesini sağlayan damlalar damlatılır. Daha sonra göz içi şeffaf ortamlar (lens ve vitreus) ile retina ayrıntılı olarak farklı aletler yardımıyla incelenir.
Retina hastalarında kullanılan tanı yöntemleri;
Biyomikroskopik ve indirekt retina muayenesi, optik koherens tomografi (OCT), renkli fundus fotoğrafı, optik koherens tomografi anjiyografisi (OCTA), FFA, indosiyanin yeşil anjiografi.
Retina hastalıklarında görmede azalma, şekilleri bozuk veya yamuk görme, yarım veya lekeli görme, siyah uçuşmalar, ışık çakması, gölgelenme, karanlıkta veya ışıkta az görme hatta hiç görmeme gibi şikâyetler ortaya çıkabilir bu durumlarla karşılaştığınızda hemen bir göz doktoruna görünmeniz önerilir.

Kontakt lensler, gözlük alternatifleri arasında en çok tercih edilen, miyopi, hipermetropi ve astigmatizma gibi kırma kusurlarını düzeltmek veya bazı kornea hastalıklarının tedavisinde kullanılan göz yüzeyine yerleştirilen ince optik lenslerdir. Gözlük kullanmak istemeyen birçok kişi tarafından tercih edilir ve bazı durumlarda kozmetik amaçlarla da kullanılır.
Doğru lens seçiminin yapılması için kontakt lens muayenesi gereklidir. Çünkü göz yapısı her kişide farklıdır ve uygun olmayan lens kullanımı kornea hasarı ve görme sorunlarına yol açabilir.

Gözümüzün dışarıdan içeriye doğru dış kısımda sklera, orta kısımda uvea, iç kısımda retina tabakalarından oluşur. Uveada gözü besleyen damarlar vardır. Uvea kısmının iltihaplanmasına üveit denir. Buranın iltihabı ciddi görme kayıplarına neden olabilir.
Bulgular gözde kızarıklık, ağrı ve bulanık görmedir. Bu durum tek taraflı ya da iki gözü birden etkileyecek şekilde olabilir. Genel olarak 20-50 yaş arasındaki kişilerde görülür, ancak nadir olarak çocukları da etkileyebilir.
Üveit mantar, virüs, parazit gibi enfeksiyon veya inflamatuar bir hastalık sebebiyle olabilir. Çoğu zaman neden belli değildir. Erken teşhisi yapılmadığında kalıcı görme kaybına sebep olabilen önemli bir hastalıktır.

Genel Göz Muayenesi Nedir? Nasıl Yapılır?
Genel göz muayenesi, göz sağlığınızı değerlendirmek ve görme ile ilgili problemleri erken dönemde tespit etmek amacıyla göz doktoru tarafından yapılan kapsamlı bir muayenedir. Miyopi, hipermetropi, astigmatizma gibi kırma kusurlarının belirlenmesi, göz hastalıklarının erken tanısı ve gerekli tedavi planlaması için son derece önemlidir.
Düzenli göz kontrolleri, glokom, katarakt ve retina hastalıkları gibi sinsi ilerleyen göz rahatsızlıklarının erken teşhisi açısından kritik rol oynar.

Kornea göze gelen ışınların retina üzerinde odaklanmasını sağlayan gözün en ön bölümündeki saydam tabakadır.
Konjonktiva, göz kapaklarının iç kısmını ve gözlerin beyaz kısmını (sklera) kaplayan, ince ve şeffaf bir zardır.
Başlıca Konjonktival ve Korneal Hastalıklar;

Glokom, genellikle göz içi basıncının artışına bağlı olarak görme sinirinde hasar oluşması ve görmenin giderek azalmasına neden olan sinsi seyirli bir göz hastalığıdır. Çoğu glokom tipi, tipik olarak ağrıya neden olmaz ve hasta tarafından görülür görme kaybı oluşana kadar hiçbir belirti vermez. Glokomun, görme siniri üzerinde yaptığı hasarın düzeltilmesi mümkün değildir. Bu nedenle görmeyi korumak için erken tanı ve tedavi önemlidir. Düzenli göz muayenesi kalıcı görme kaybı meydana gelmeden önce glokomu tespit etmenin tek yoludur. Bebeklerde ve genç yaşlarda da glokom görülebilir.
40 yaş üzeri herkes yılda en az bir kez kontrol olmalı ve göz tansiyonunu ölçtürmelidir.
Mayagöz kliniğimize müracaat eden her hasta glokom yönünden değerlendirilmektedir. Muayene sonrasında glokom (göz tansiyonu) şüphesi olan veya glokom tanısı alan hastalara ileri tetkik yapılmaktadır.

Kuru Göz Hastalığı, gözlerin gözyaşı ile yeterince nemlendirilememesi sonucu ortaya çıkan ve yaşam kalitesini etkileyen yaygın bir göz sağlığı problemidir. Gözyaşı üretimi yetersiz olabilir veya gözyaşı filmi yapısal sorunlar nedeniyle göz yüzeyinde stabil kalamayabilir.
Gözyaşı filmi yağ, sulu ve mukus olmak üzere üç tabakadan oluşur. Bu tabakalardan herhangi birindeki bozulma kuru göz sendromu gelişmesine neden olur.
Kuru göz oluşumunda çevresel, sistemik ve yapısal birçok faktör etkili olabilir.

Refraktif cerrahi, genellikle göz bozukluklarını düzeltmek amacıyla yapılan cerrahi işlemleri ifade eder. Göz bozuklukları arasında miyopi (uzak gözlükleri iyi göremez), hipermetropi (yakın gözlükleri iyi göremez), astigmatizma (göz yuvarlağının veya korneanın düzensiz şekli nedeniyle oluşan odaklanma sorunu) ve presbiyopi (yaşa bağlı olarak yakını görememe) bulunur.
Yaygın refraktif cerrahi yöntemleri genellikle;
Fakik Göz İçi Lensi Uygulamaları
Gözlük kullanmak istemeyen, kontakt lens kullanamayan hastalar, excimer laser için kornea yapısı uygun olmayan veya gözlük numarası çok yüksek olup excimer cerrahi sınırları dışında olan, göz yapısı uygun hastalarda kullanılan yöntemdir. Bu yöntemde 25 numaraya kadar miyop, 10 numaraya kadar hipermetrop ve 6 numaraya kadar da astigmat tedavi edilebilmektedir.

Değerli Ziyaretçimiz,
Kişisel verilerin işlenmesinde başta özel hayatın gizliliği olmak üzere kişilerin temel hak ve özgürlüklerini korumak ve kişisel verileri işleyen gerçek ve tüzel kişilerin yükümlülükleri ile uyacakları usul ve esasları düzenlemek amacıyla kabul edilen 6698 Sayılı Kişisel Verilerin Korunması Kanunu (KVKK); 7 Nisan 2016 tarihli Resmi Gazete’de yayınlanmış ve ilgili yürürlük maddesi uyarınca anılan kanunun 8 inci, 9 uncu, 11 inci, 13 üncü, 14 üncü, 15 inci, 16 ncı, 17 nci ve 18 inci maddeleri 07 Ekim 2016 tarihinden itibaren yürürlüğe girmiştir.
Mayagöz Şirketi olarak , kişisel verilerinizin güvenliğinin sağlanmasına çok büyük önem göstermekteyiz. Kişisel verileriniz Şirketimiz tarafından, 6698 sayılı Kişisel Verilerin Korunması Kanunu’nda (KVKK veya Kanun) yer alan temel ilkelere ve kişisel veri işleme şartlarına uygun olarak işlenmektedir. İşbu Kişisel Verileri İşleme ve Gizlilik Politikası ile Aydınlatma Metni, verilerin korunması için her türlü önlemi alan ve azami hassasiyet gösteren bir şirket olarak, kişisel verilerinizin işlenmesi hususunda siz değerli ziyaretçilerimizi belirlemiş olduğumuz Kişisel Verileri İşleme ve Gizlilik Politikası hakkında aydınlatmak amacıyla kaleme alınmıştır. Bu doğrultuda, kişisel verileri metinde yazan ancak bunlarla sınırlı olmayan bir şekilde işlenecek, ziyaretçileri, şirket yetkilileri, şirket çalışanları, çalışan adayları, iş ve/veya hizmet ilişkisi içinde olduğumuz kurumlar, kurumların çalışanları, hissedarları ile yetkilileri ve ilgili diğer tüm üçüncü kişiler bakımından işbu Kişisel Verileri İşleme ve Gizlilik Politikası ile Aydınlatma metni düzenlenmiştir.
A. Tanımlar
İşbu Kişisel Verileri İşleme ve Gizlilik Politikası ile Aydınlatma metni kapsamında kullanılmış olan terim ve kısaltmalara ilişkin tanımlar aşağıdaki gibidir:
| Kısaltma | Tanım |
| Açık Rıza: | Belirli bir konu ile ilgili, bilgilendirmeye dayanan ve ilgili kişinin özgür iradesi ile vermiş olduğu rızadır. |
| Anonim Hale Getirme: | İşlenen kişisel verilerin, başka verilerle eşleştirilerek dahi hiçbir surette kimliği belirli veya belirlenebilir bir gerçek kişi ile ilişkilendirilemeyecek hale getirilmesidir. |
| İlgili kişi: | Kişisel verisi işlenen gerçek kişidir. |
| Kişisel Veri: | Kimliği belirli veya belirlenebilir gerçek kişiye ilişkin her türlü bilgidir. |
| Kişisel verilerin işlenmesi: | Kişisel verilerin tamamen veya kısmen otomatik olan ya da herhangi bir veri kayıt sisteminin parçası olmak kaydıyla otomatik olmayan yollarla elde edilmesi, kaydedilmesi, depolanması, muhafaza edilmesi, değiştirilmesi, yeniden düzenlenmesi, açıklanması, aktarılması, devralınması, elde edilebilir hâle getirilmesi, sınıflandırılması ya da kullanılmasının engellenmesi gibi veriler üzerinde gerçekleştirilen her türlü işlemdir. |
| Veri işleyen: | Veri sorumlusunun verdiği yetkiye dayanarak onun adına kişisel verileri işleyen gerçek veya tüzel kişidir. |
| Veri sorumlusu: | Kişisel verilerin işleme amaçlarını ve vasıtalarını belirleyen, veri kayıt sisteminin kurulmasından ve yönetilmesinden sorumlu olan gerçek veya tüzel kişidir. |
| Ziyaretçi | Şirketimizin fiziksel mekânlarını veya internet sitesini hangi amaçla olduğu fark etmeksizin ziyaret etmiş gerçek kişilerdir. |
B. Kişisel Verileri İşleme İlkelerimiz
Şirketimiz, Kanun’a uygun olarak toplamış olduğu kişisel verilerin işlenmesi konusunda Kanun ve ilgili sair mevzuatta belirlenen genel ilkeler ile öngörülen usul ve esaslar çerçevesinde hareket etmektedir. Bu kapsamda Şirketimiz, işbu verilerin korunması ve işlenmesi sırasında Kanun’un 4. Maddesine uygun olarak aşağıdaki ilkelere uygun davranacağını beyan ve taahhüt etmektedir:
a) Hukuka ve dürüstlük kurallarına uygun olma,
b) Doğru ve gerektiğinde güncel olma,
c) Belirli, açık ve meşru amaçlar için işlenme,
ç) İşlendikleri amaçla bağlantılı, sınırlı ve ölçülü olma,
d) İlgili mevzuatta öngörülen veya işlendikleri amaç için gerekli olan süre kadar muhafaza edilme.
C. Aydınlatma Yükümlülüğü
KVKK Madde 10, veri sorumlularına, verileri işlenen ilgili kişilerin bu hususta onayları alınırken aydınlatma yükümlülüğünün yerine şart koşmaktadır. Kanunun işbu maddesi uyarınca veri sorumlusu sıfatına sahip olan Şirketimiz, ilgili kişileri;
Söz konusu bilgilendirme, işbu Kişisel Verileri İşleme ve Gizlilik Protokolü ile Aydınlatma Metni ile gerçekleştirilmekte olup gerekli açıklamalarımız aşağıda yer almaktadır.
D. Kişisel Verilerin Toplanması, İşlenmesi, İşlemenin Amacı ve Hukuki Sebepleri:
Kişisel verileriniz, KVKK Madde 5 uyarınca ancak siz ziyaretçilerimizin açık rızası veya aşağıda belirtilen kanuna uygunluk hallerinden birinin varlığı halinde işlenmektedir. Bunlar;
Kişisel verileriniz; Şirketimiz tarafından sunulan hizmetlerden yararlanan, iş ve/veya ticaret ilişkisi içerisinde bulunan kişilerin her türlü hukuki güvenliğinin temini için gerekli çalışmaların yapılması, Şirketimizin ticari ve iş stratejilerinin belirlenmesi ve uygulanması, Şirketimizin insan kaynakları politikalarının yürütülmesinin temini, fiziksel ortamların güvenliğinin sağlanması, müşteri ilişkilerinin yürütülmesi, müşteri iletişim bilgilerinin güncellenmesi, mali yükümlülüklerin yerine getirilmesi, reklam ve tanıtım faaliyetlerinde bulunulabilmesi, müşteri şikâyet ve ihtiyaçlarının analiz edilebilmesi amacıyla ve KVKK Kişisel Verilerin Korunması Kanununun 5. maddesinde belirtilen veri sorumlusunun hukuki yükümlülüğünün yerine getirmesine dayalı olarak; sağlanılan hizmet, iş ve/veya ticari faaliyetlere bağlı olarak değişkenlik gösterebilecek olmakla birlikte; internet sitesi, e-posta, sosyal medya mecraları, mobil uygulamalar, pazarlama çalışmaları, güvenlik kameraları, müşteri şikâyet formları, Şirketimiz ile iş ve/veya ticaret ilişkisi içerisinde bulunan gerçek ve/veya tüzel kişiler ile bu kişilerle birlikte ve/veya adına çalışan kişiler tarafından kişisel verilere ilişkin bilgilendirme yapılması, Şirketimizin birimlerinde çalışmak üzere iş başvurusu ile ve/veya çalışmaya başlanması sebebiyle, veri sahibinin kişisel verileri ile ilgili bilgilendirme yapması aracılığı ile sözlü, yazılı veya elektronik ortamda toplanabilmektedir.
Şirketimiz, Kanun’a uygun olarak toplamış olduğu kişisel verilerin işlenmesi konusunda, Kanun ve ilgili sair mevzuatta belirlenen genel ilkeler çerçevesinde hareket etmektedir. Şirketimiz, işbu verilerin korunması ve işlenmesi sırasında Kanun’un 4. Maddesine uygun bir şekilde, her türlü kişisel veri işleme sürecinde, hukuka ve dürüstlük kurallarına uygun davranacak ve orantılılık ilkesinin gereklerini gözetecek, işlediği her türlü kişisel verinin doğru ve güncel olmasını sağlayacak ve bu doğrultuda gerekli tüm tedbirleri alacak, veri işleme faaliyetlerini ancak belirli, açık ve meşru amaçlarla sınırlı tutacak, elde ettiği kişisel verileri ancak işlendiği amaçla bağlantılı, sınırlı ve ölçülü şekilde işleyebilecek, kişisel verileri ancak belirlenen amaçların gerçekleştirilebilmesi için elverişli olduğu takdirde işlenebilecek ve bu amaçlar sonradan ortaya çıkması muhtemel ihtiyaçların karşılanması için genişletilemeyecek olup; bu ilkelere uygun davranacağını beyan ve taahhüt etmektedir.
E. Kişisel Verilerin Saklanması
Şirketimiz tarafından, KVK Kanunu’nun 1. Ve 2. Maddeleri uyarınca toplanan kişisel veriler, şirketin ticari faaliyetlerinin yerine getirilebilmesi amacıyla, uygun süre zarfında fiziksel veya elektronik ortamda güvenli bir şekilde saklanmaktadır. Söz konusu faaliyetler kapsamında, Şirketimiz tarafından kişisel verilerin korunmasına ilişkin olarak KVKK öncelikli olmak üzere, ilgili tüm mevzuatta öngörülen tüm yükümlülüklere uygun hareket edilmektedir. İlgili mevzuat uyarınca, kişisel verilerin daha uzun süre saklanmasına müsaade edilen veya saklanması zorunlu olan haller dışında, kişisel verilerin işlenme amaçlarının sona ermesi durumunda, re’sen veya veri sahibinin başvurusu üzerine veriler silinecek, yok edilecek veya anonim hale getirilecektir. Kişisel verilerin çeşitli yöntemler ile yok edilmesi durumunda, bu veriler tekrar hiçbir şekilde kullanılamayacak ve geri getirilemeyecek şekilde imha edilecektir.
Ancak veri sorumlusunun meşru menfaatinin bulunduğu durumlarda, işleme amacının ve ilgili mevzuatta belirtilen sürelerin de sona ermesine rağmen veri sahiplerinin temel hak ve özgürlüklerine zarar vermemek şartıyla kişisel veriler, Kişisel Verilerin Saklanma ve İmha Politikamızda belirlenen süre kadar saklanabilecektir. Bahsi geçen sürelerin sona ermesinin ardından kişisel veriler, yukarıda belirtilen şekilde silinecek, yok edilecek veya anonim hale getirilecektir. Kişisel Verilerin Saklanma ve İmha Politikamız’a buradan ulaşabilirsiniz.
F. İşlenen Kişisel Verilerin Aktarılması
Toplanan kişisel verileriniz; Şirketimiz tarafından sunulan hizmetlerden sizleri faydalandırmak için gerekli çalışmaların yapılması, sunulan hizmetlerin sizlerin beğeni, kullanım alışkanlıkları ve ihtiyaçlarına göre özelleştirilerek sizlere önerilmesi, Şirketimizin ve Şirketimizle iş ve/veya ticaret ilişkisi içerisinde olan kişilerin hukuki ve ticari güvenliğinin temini (Şirketimiz tarafından yürütülen iletişime yönelik idari operasyonlar, Şirkete ait lokasyonların fiziksel güvenliğini ve denetimini sağlamak, iş ortağı/müşteri/tedarikçi/taşeron (yetkili veya çalışanları) değerlendirme süreçleri, itibar araştırma süreçleri, hukuki uyum süreci, denetim, mali işler vb.), Şirketimizin ticari ve iş stratejilerinin belirlenmesi ve uygulanması, Şirketimizin insan kaynakları politikalarının yürütülmesinin temini ile Kanuni yükümlülüklerin yerine getirilmesi amacıyla, iş ortaklarımıza, tedarikçilerimize, Şirket yetkililerine, hissedarlarımıza, kanunen yetkili kamu kurumları ve özel kişilere, KVK Kanunu’nun 8. ve 9. maddelerine doğrultusunda yurt içine ve/veya yurt dışına, veri sahibinin açık rızası ile ve/veya aynı maddelerde belirtilen hallerden bir veya birkaçının varlığı halinde açık rıza aranmaksızın aktarılabilmektedir.
G. Veri Sahibinin Hakları
Kişisel veri sahipleri olarak, haklarınıza ilişkin taleplerinizi, işbu Kişisel Verileri İşleme ve Gizlilik Politikası ile Aydınlatma Metninde düzenlenen veya KVKK’da belirtilen yöntemlerle, Şirketimize iletmeniz durumunda Şirketimiz talebin niteliğine göre talebi en geç otuz gün içinde sonuçlandıracaktır. Şirketimiz, işbu başvurunuzu ücretsiz olarak sonuçlandıracaktır. Ancak, Kişisel Verileri Koruma Kurulunca bir ücret öngörülmesi halinde, Şirketimiz tarafından belirlenen tarifedeki ücret alınacaktır. KVKK madde 11 uyarınca kişisel veri sahipleri;
Yukarıda belirtilen haklarınızı kullanmak için KVKK’nın 11. maddesinde belirtilen haklardan kullanmayı talep ettiğiniz hakkınıza yönelik açıklamalarınızı içeren talebinizi ekte bulunan başvuru formunu doldurarak, formun imzalı bir örneğini Mayagöz adresine kimliğinizi tespit edici belgeler ile bizzat elden teslim edebilir veya iadeli taahhütlü posta yolu ile, noter kanalıyla veya KVKK’da belirtilen diğer yöntemler ile gönderebilirsiniz.
İletişim Adres:
E Posta: hastahizmetleri@mayagoz.com
